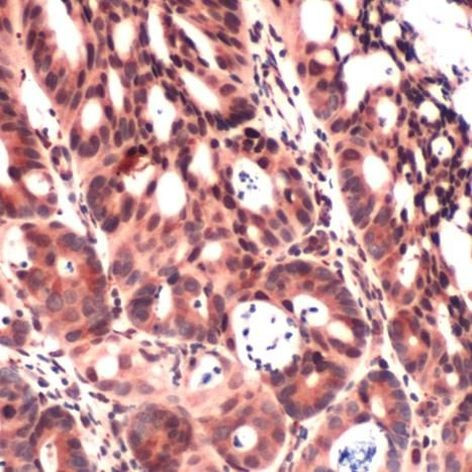
IGF2 Antibody in Immunohistochemistry (IHC)

Search
Invitrogen
IGF2 Polyclonal Antibody
{{$productOrderCtrl.translations['antibody.pdp.commerceCard.promotion.promotions']}}
{{$productOrderCtrl.translations['antibody.pdp.commerceCard.promotion.viewpromo']}}
{{$productOrderCtrl.translations['antibody.pdp.commerceCard.promotion.promocode']}}: {{promo.promoCode}} {{promo.promoTitle}} {{promo.promoDescription}}. {{$productOrderCtrl.translations['antibody.pdp.commerceCard.promotion.learnmore']}}
产品信息
PA5-32547
宿主/亚型
分类
类型
抗原
偶联物
形式
保存条件
运输条件
RRID
产品详细信息
Heat-mediated antigen retrieval is recommended prior to staining, using a 10mM citrate buffer, pH 6.0, for 10 minutes followed by cooling at room temperature for 20 min. Following antigen retrieval, incubate samples with primary antibody for 30 min at room temperature. A suggested positive control is rectal carcinoma.
靶标信息
The IGFs are mitogenic, polypeptide growth factors that stimulate the proliferation and survival of various cell types, including muscle, bone, and cartilage tissue in vitro. IGFs are predominantly produced by the liver, although a variety of tissues produce the IGFs at distinctive times. The IGFs belong to the Insulin gene family, which also contains insulin and relaxin. The IGFs are similar to insulin by structure and function, but have a much higher growth-promoting activity than insulin. IGF-II expression is influenced by placenta lactogen, while IGF-I expression is regulated by growth hormone. Both IGF-I and IGF-II signal through the tyrosine kinase type I receptor (IGF-IR), but IGF-II can also signal through the IGF-II/Mannose-6-phosphate receptor. Mature IGFs are generated by proteolytic processing of inactive precursor proteins, which contain N-terminal and C-terminal propeptide regions.
仅用于科研。不用于诊断过程。未经明确授权不得转售。